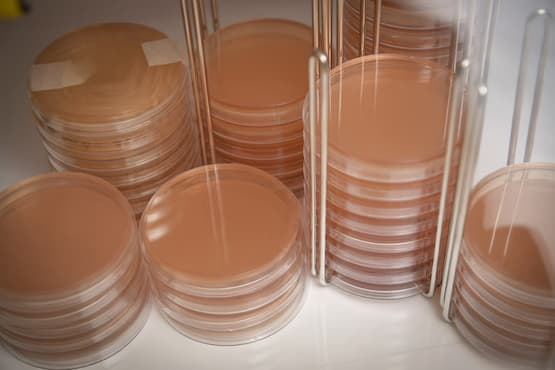

Media release
From:
Key points
- Hydrogen gas is produced in the gut, with some expelled as flatulence
- Researchers have shed new light on how gut microbes make and use hydrogen
- This will help in understanding and maintaining overall gut health
Farts are causing a stink in the research world, but in a positive way.
Melbourne scientists have revealed how hydrogen is made and used in the human gut. Though infamous for making farts ignite, hydrogen also has a positive role supporting gut health.
In this study published in Nature Microbiology, researchers from Monash University and Hudson Institute of Medical Research led an international team that analysed how microbes control hydrogen levels in the gut.
Hydrogen gas is naturally produced in the gut when bacteria ferment undigested carbohydrates from our diets. Some of this gas is exhaled, much is recycled by other gut bacteria, and the rest exits the body as flatulence.
First author Dr Caitlin Welsh, who was co-hosted by Monash University and Hudson Institute of Medical Research, said the results revealed hydrogen had an even bigger role in gut function than previously thought.
“Most people release about a litre of gas per day and half of that is hydrogen. But hydrogen is more than just the gas behind flatulence – it’s a hidden driver of gut health,” Dr Welsh said. “Our study shows hydrogen shapes the gut microbiome in surprising and varied ways. It helps some beneficial bacteria thrive in the gut and keeps digestion going.”
The researchers hope their discovery will highlight the need to expand fundamental knowledge of how our gut works so it can be used to design new treatments for gastrointestinal issues.
Co-senior author Professor Chris Greening, who leads the One Health Microbiology group at Monash University’s Biomedicine Discovery Institute, said hydrogen was central to gut function.
“Gas production in the gut is a normal process. Hydrogen is made in large amounts when gut bacteria break down food and is then used by other microbes for energy,” Professor Greening said.
However, excessive hydrogen production can signal gut problems. Abnormal hydrogen levels are associated with infections, digestive disorders, and even cancer, and are often measured in breath tests to assess gut health.
“We also saw signs that hydrogen production was disrupted in people with gut disorders, but it’s unclear if this is a cause or consequence of disease,” Professor Greening said.
The researchers’ work was focused on understanding the fundamental role of hydrogen in gut function, rather than improving diagnostics or developing therapies.
Co-senior author Associate Professor Sam Forster, who leads Hudson Institute’s Microbiota and Systems Biology Laboratory and has an appointment with Monash University’s Department of Molecular and Translational Sciences in the School of Clinical Sciences, said the newly discovered links could nevertheless help understanding of gut conditions and guide development of new microbiome-based treatments.
Associate Professor Forster said while emerging microbiome-based therapies ranged from faecal transplant and probiotics to live biotherapeutics, we had a long way to go to fully understand how they worked and how best to use them.
“By understanding the functions of these systems, it opens up new opportunities for therapeutic interventions, some of which we haven’t even considered,” he said.
What the research discoveredThe study found that a specific enzyme called Group B [FeFe]-hydrogenase was mainly responsible for making hydrogen in the gut. This enzyme is found in many gut bacteria and is very active. The researchers studied bacteria from stool samples and gut tissue and found that this enzyme helps bacteria grow and produce hydrogen, especially in the primary health associated groups. They also discovered that this enzyme works by using a specific chemical reaction involving iron and another protein called ferredoxin. As an example, healthy people have a lot of these enzymes in their gut, but people with Crohn’s disease have fewer of them and more of other types of hydrogen-producing enzymes.
Read the research paper, published in Nature Microbiology, A widespread hydrogenase supports fermentative growth of gut bacteria in healthy peopleDOI: 10.1038/s41564-025-02154-w
This research involved Monash University’s Biomedicine Discovery Institute, the Hudson Institute of Medical Research, Upsala University, the University of Melbourne, The Peter Doherty Institute for Infection and Immunity, Harvard University, The University of Illinois Urbana-Champaign, the University of Michigan, and Purdue University.



 Australia; VIC
Australia; VIC